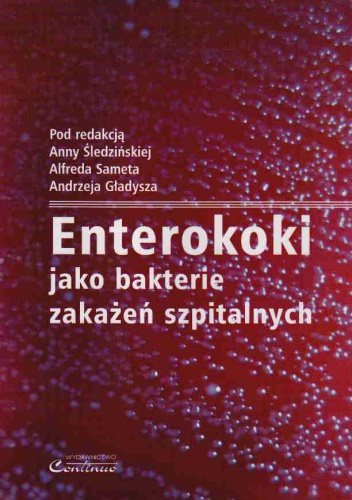
Enterokoki jako bakterie zakażeń szpitalnych

Enterokoki jako bakterie zakażeń szpitalnych
- Kategoria
- Dodał
-
- ebook
- pobierz
- mobi
- epub
Aby uzyskać dostęp do całego serwisu zarejestruj się!
Rejestracja jest darmowa i bardzo szybka! Kliknij tutaj aby założyć konto. Trwa to tylko 15 sekund!.
Rejestracja jest darmowa i bardzo szybka! Kliknij tutaj aby założyć konto. Trwa to tylko 15 sekund!.
chomikuj, do pobrania pdf
